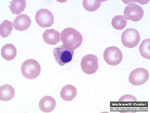
Η αναιμία αυξάνει τον κίνδυνο εγκεφαλικού επεισοδίου στα μικρά παιδιά

Κίνδυνος εγκεφαλικού επεισοδίου μετά από έρπη ζωστήρα
Νέα Υόρκη: Ο έρπης ζωστήρας αυξάνει τον κίνδυνο εγκεφαλικού επεισοδίου το επόμενο χρόνο απο την εκδήλωση του έως και κατά 30% και πάνω απο 400% σε περίπτωση που η λοίμωξη περιλαμβάνει και το δέρμα γύρω από τα μάτια, σύμφωνα με μελέτη Ταϊβανών ερευνητών που δημοσιεύεται στο επιστημονικό έντυπο Stroke.

Αριθμός Πιστοποίησης Μ.Η.Τ.232442
Αριθμός Πιστοποίησης Μ.Η.Τ.232442